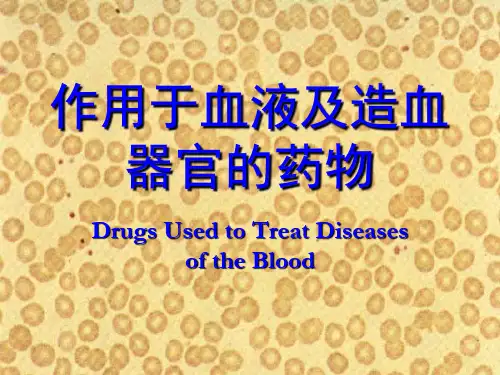

药理学 第31章 血液系统药[1]
- 格式:ppt
- 大小:556.00 KB
- 文档页数:35


血液系统药物作用于血液系统的药物1. 血栓—抗血栓药(抗凝血药、抗血小板药、促纤溶药)2. 出血—促凝血药(维生素K、血浆制剂、纤维蛋白溶抑制药)3. 抗贫血药(铁制剂、叶酸及维生素B12)4. 造血生长因子5. 血浆代用品(右旋糖苷)6. 白血病治疗药物----抗肿瘤药(伊马替尼等)7. 白细胞减少----升白药血液凝固凝血过程包括:内源性凝血途径外源性凝血途径共同凝血途径血栓的形成Ø血管壁改变,内皮细胞的损伤Ø血液成分变化,血小板活化,凝血因子激活、纤维蛋白形成Ø血流状态的改变:缓慢,涡流纤维蛋白溶解系统的调节Ø血液的流动性与凝固性的调节Ø凝血与抗凝机制Ø纤维蛋白溶解系统与抗纤溶机制Ø保持动态平衡,共同维持血液的流动性抗血栓药一、抗凝血药(Anticoagulants)二、抗血小板药(Antiplatelet drugs)三、纤维蛋白溶解药(Fibrinolytics)抗凝血药Ø凝血酶间接抑制药:肝素Ø维生素K拮抗药:香豆素类Ø新型口服抗凝药:达比加群酯、~~沙班(1)凝血酶间接抑制药——肝素(Heparin)存在于肥大细胞、血浆及血管内皮细胞中含大量硫酸基和羧基,带大量负电荷,呈强酸性(抗凝作用的基础)体内过程:注射用抗凝血药高极性,大分子→ 注射给药1、抗凝作用Ø机制:Heparin的抗凝机制由抗凝血酶Ⅲ(AT-Ⅲ)介导增强AT-Ⅲ的作用(灭活凝血因子Ⅱa、Ⅸa、Ⅹa、Ⅺa、Ⅻa、Ka、纤溶酶) 肝素-ATⅢ-凝血因子复合物(灭活以上各因子)肝素-ATⅢ-凝血因子复合物Ø高剂量的Heparin也抑制血小板聚集Ø体内、体外均有抗凝作用Ø起效迅速、作用强2、抗动脉粥样硬化作用降血脂保护动脉内皮抗平滑肌细胞增殖3、抗炎作用抑制白细胞游走、趋化、粘附中和多种致炎因子减少氧自由基形成灭活多种酶等临床应用1、用于防治血栓栓塞性疾病防治心肌梗死、脑梗死、心血管手术及外周静脉术后血栓2、弥散性血管内凝血(disseminated intravascular coagulation,DIC)3、体外抗凝不良反应1、出血是heparin最常见的不良反应,发生5-10%2、血小板减少症发生率5-6%3、其他偶有过敏反应;久用可引起脱发、骨质疏松、骨折等肝素的特效解毒剂——鱼精蛋白化学特性:强酸性,具强负电荷(抗凝作用基础)。

药理学习题第31章汇总内脏系统药理学试题第31章作用于血液及造血器官药⒈掌握抗凝血药肝素和华法林的药理作用及其临床应用,不良反应及其防治。
⒉熟悉纤维蛋白溶解药链激酶和尿激酶及组织型纤溶酶原激活因子的药理作用及临床应用。
⒊了解抗贫血药(铁剂、叶酸、维生素B12)、促凝血药(维生素K)、抗纤维蛋白溶解药(氨甲苯酸、氨甲环酸)、抗血小板药(双嘧达莫、噻氯匹定)、促白细胞增生药的药理作用及临床应用掌握抗凝血药、促凝血药,抗贫血药作用特点及原理及血容量扩张剂药理作用,临床应用和不良反应。
名词解释1.促凝血药2.抗凝血药单项选择题A型题1.铁制剂主要用于治疗A.溶血性贫血B.巨幼红细胞性贫血C.再生障碍性贫血D.小细胞低色素性贫血E.自身免疫性贫血2.治疗慢性失血所致贫血宜选用A.维生素B12B.叶酸C.铁剂D.维生素CE.甲酰四氢叶酸钙3.妨碍铁剂在肠道吸收的物质是A.稀盐酸B.维生素CC.半胱氨酸D.果糖E.鞣酸4.肝素过量引起自发性出血的对抗药是 A.鱼精蛋白B.维生素KC.垂体后叶素D.氨甲苯酸E.右旋糖酐5.治疗香豆素类药过量引起的出血宜选用 A.鱼精蛋白B.维生素KC.维生素CD.垂体后叶素E.右旋糖酐6.治疗尿激酶过量引起的出血宜选用A.鱼精蛋白B.维生素KC.维生素CD.氨甲苯酸E.右旋糖酐7.治疗急性肺栓塞宜选用A.肝素B.双香豆素C.右旋糖酐D.尿激酶E.枸橼酸钠8.下列关于肝素的叙述错误的是A.口服无效B.体内外均有效C.主要以原形从肾排泄D.可通过胎盘屏障E.具有降血脂作用9.肝素抗凝作用的主要机制是A.直接灭活凝血因子B.激活抗凝血酶ⅢC.抑制肝合成凝血因子D.激活纤溶酶原E.与血中Ca2+络合10.华法林的特点是A.口服无效B.作用持续时间较长C.起效快D.体内外均有效E.血浆蛋白结合率低11.下列关于铁剂应用时的注意事项错误的是A.为减轻胃肠道反应,宜与抗酸药同时服用B.与维生素C合用可促进吸收C.服用铁剂时不宜喝浓茶D.不宜与四环索类同服E.血红蛋白恢复正常后,不宜立即停药 12.香豆素类药抗凝作用机制是A.妨碍肝合成凝血因于Ⅱ、Ⅷ、Ⅸ、Ⅹ B.耗竭体内凝血因子C.激活血浆中抗凝血酶mD.抑制纤溶酶原变为纤溶酶E.抑制凝血酶原转变为凝血酶13.乙酰水杨酸抗栓作用的机制是A.抑制磷脂酶A2,因而减少TXA2的产生 B.抑制脂氧酶,因而减少TXA2的产生 C.抑制环氧酶,因而减少TXA2的产生 D.抑制TXA2合成酶,因而减少TXA2的产生E.以上均不是14.氨甲苯酸的作用机制是A.诱导血小板聚集B.收缩血管C.激活血浆中的凝血因子D.抑制抗凝血酶Ⅲ的活性E.抑制纤溶酶原激活因子15.可降低双香豆素抗凝作用的药物是A.乙酰水杨酸B.保泰松C.广谱抗生素D.苯巴比妥E.链激酶16.胰腺手术后的出血宜选用的止血药是A.维生素KB.鱼精蛋白C.氨甲苯酸D.垂体后叶素 E.以上均不是17.苯妥英钠与双香豆素合用,后者作用A.增强B.减弱C.起效加快D.持续时间延长E.吸收增加18.恶性贫血宜选用A.铁剂B.维生素B12C.维生素B6D.维生素B12+叶酸E.叶酸19.治疗甲氨蝶呤所致巨幼红细胞性贫血宜选用A.叶酸B.维生素B12C.铁剂D.右旋糖酐E.甲酰四氢叶酸钙20.用于防治静脉血栓的口服药物是A.肝素B.华法令C.链激酶D.枸橼酸钠E.尿激酶21.最常用于静脉注射给药的抗凝药是A.新抗凝B.华法林C.肝索D.枸橼酸钠E.双嘧达莫22.下述哪项不是抗凝血药的禁忌证?A.消化性溃疡B.严重高血压C.肝肾功能不全D.活动性肺结核E.心肌梗塞23. 肝素的抗凝作用()A 仅在体内有效B 仅在体外有效C 体内、体外均有效D 仅口服有效E 以上都不对24. 下列关于肝素的描述,正确的是()A 维生素K可以对抗B 必须口服才有效C 溶液中带强正电荷D 加速抗凝血酶Ⅲ中和灭活凝血因子Ⅱa和XaE 仅在体内有作用25. 长期应用肝素出现的不良反应是()A 便秘B 消化性溃疡C 视觉模糊D 心律失常E 骨质疏松26. 肝素及香豆素类药物均可用于()A 弥散性血管内凝血B 防治血栓栓塞性疾病C 体外循环D 抗高血脂症E 脑溢血27.可增强双香豆素抗凝作用的药物是()A 广谱抗生素B 青霉素GC 氯化铵D 维生素CE 苯巴比妥28. 华法林的对抗药物是()A 鱼精蛋白B 氨甲苯酸C 凝血酶D 维生素KE 烟酸29.只用于体外抗凝的抗凝血药是()A 肝素B 华法林C 新抗凝D 枸橼酸钠E 尿激酶30. 治疗纤维蛋白溶解亢进所致出血宜选用()A 鱼精蛋白B 维生素KC 氨甲苯酸D 酚磺乙酸E 以上都不是31. 尿激酶抗凝血作用原理是()A 直接激活纤溶酶原激活酶B 直接降解纤维蛋白C 促进纤溶酶原激活因子前体转变为激活因子D 激活纤溶酶E 直接激活纤溶酶原32. 血液透析患者宜采用的抗凝血药物是()A 枸橼酸钠B 华法林C 双香豆素乙酯D 肝素E 双嘧达莫33. 关于香豆素类抗凝药的特点,下列哪项是错误的()A 口服有效B 起效缓慢、但作用持久C 体内、体外均有抗凝作用D 对已合成的凝血因子Ⅱ、Ⅶ、Ⅸ、Ⅹ无对抗作用E 剂量必须按凝血酶原时间个体化34. 男,33岁,嗜烟15年以上,20天来,出现左踝关节以下皮肤温度明显降低,皮肤苍白,足背动脉搏动消失,诊断为左下肢动脉栓塞,用下列哪种药物治疗最好()A 口服华法林B 肝素静脉同时口服华法林C 尿激酶左股动脉注射并给予肝素和华法林抗凝治疗D 口服阿斯匹林E 度冷丁止痛、口服阿斯匹林35.香豆素类药物的作用特点,除外是()A 起效慢、作用时间长B 合用阿斯匹林有协同作用C 体外无抗凝作用D 中毒时应该用钙剂解救E 对已形成的凝血因子无抑制作用36. 维生素K对以下哪种疾病所致的出血无效()A 梗阻性黄疸B 新生儿出血C 继发性凝血酶原缺乏D 双香豆素过量E 严重肝硬化37. 下列哪个药不用于治疗血栓栓塞性疾病()A 肝素B 双香豆素C 阿斯匹林D 噻氯吡定E 氨甲苯酸38. 下列哪一项不是右旋糖酐的药理作用()A 补充血容量B 抗休克C 改善微循环D 渗透性利尿作用E 降低血压B 型题A.新生儿出血B.遗传性出血性疾病C.前列腺手术后出血D.冠心病E.缺铁性贫血39.氨甲环酸用于40.凝血因子制剂用于41.维生素K用于A.硫酸亚铁B.叶酸C.维生素B12D.甲酰四氢叶酸钙E.右旋糖酐42.营养性巨幼红细胞性贫血宜选用43.月经过多所致的贫血宜选用44.恶性贫血选用45.乙氨嘧啶所致的贫血宜选用46,失血性休克为扩充血容量宜选用47.神经炎的辅助治疗宜选用A 肝素B 枸橼酸钠C 尿激酶D 氨甲苯酸E 华法林48. 心血管手术抗凝一般选用()49 .将纤溶酶原激活为纤溶酶的药物是()50. 纤维蛋白溶解症所致的出血()多选题1.右旋糖酐具有下列作用A 恶性贫血B阻止红细胞、血小板聚集C渗透性利尿作用D改善微循环E扩充血容量2.关于铁剂的叙述错误的是A维生素C可促进铁吸收B Fe3+比Fe2+更易吸收C多钙、高磷酸盐食物可妨碍铁吸收D食物中的铁主要在胃中吸收E可治疗慢性失血性贫血3.维生素B12的临床应用是 A恶性贫血B营养性巨幼红细胞性贫血C 慢性失血性贫血D神经炎E抗凝血4.双香豆素抗凝血作用的特点是A 体内无效B体外无效C作用持久D 起效慢E 口服有效问答题1.试述肝素与双香豆素的异同。

血液系统药教学课件-V1
血液系统药教学课件
随着医学的发展和进步,人们对血液系统药的认识和应用越来越深入。
血液系统药是一类具有特殊药理作用的药品,主要用于治疗血液系统
疾病和改善血液系统功能。
为了帮助学生更好地掌握血液系统药的知识,我特意制作了血液系统药教学课件,下面就来介绍一下这份课件
的主要内容。
一、血液系统药的分类
根据药理作用和治疗对象,血液系统药可以分为抗凝剂、止血剂、抗
贫血剂、生长因子、造血干细胞移植等几类。
在课件中需要详细介绍
每一类药物的作用、适应症和注意事项等。
二、氨甲环酸的药理作用
氨甲环酸是一种常用的抗凝剂,可以有效地预防和治疗一些血栓性疾病,如深静脉血栓、肺栓塞等。
在课件中需要介绍氨甲环酸的药理作用、适应症、剂量和不良反应等。
三、止血剂的分类
止血剂根据其作用机制和临床应用可以分为局部止血剂和全身止血剂。
局部止血剂主要用于局部创伤的止血,如凝血酶、明胶海绵等。
全身
止血剂则主要用于血友病、血小板减少性紫斑病等疾病的治疗。
在课
件中需要介绍每种止血剂的作用机制、适应症和使用方法等。
四、铁剂的临床应用
铁剂是一种常用的抗贫血剂,主要用于治疗缺铁性贫血。
在课件中需
要介绍铁剂的药理作用、适应症、使用方法和不良反应等。
五、课件示范
在课件结尾,可以加入一些案例分析或模拟临床操作,帮助学生更好地掌握血液系统药的应用。
总之,血液系统药教学课件需要系统地介绍血液系统药的分类、药理作用、临床应用以及注意事项等,结合案例分析和模拟操作,帮助学生更好地了解和掌握相关知识。